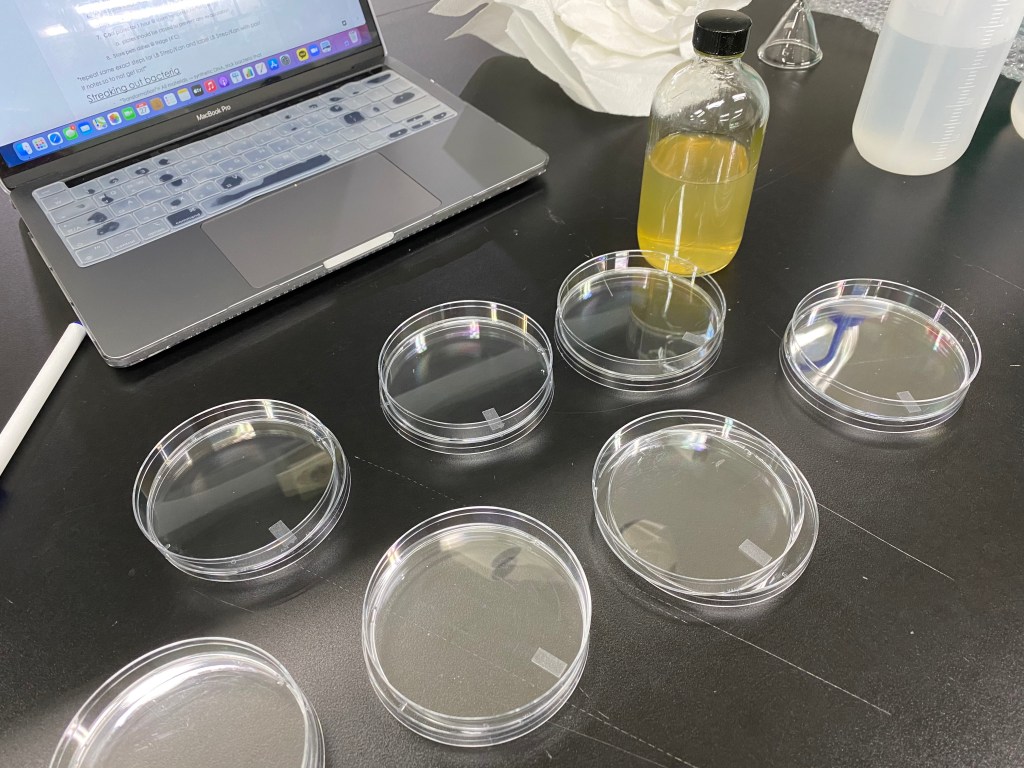

My school hosts an annual project for all high school students called NPCS, the New Pacific Century Scholars Program, where students are allowed to choose between a research project, a career exploration (originally was internship but changed to career exploration due to COVID), and community service.
I chose my project to be in the Research & Discovery category because especially in times of COVID where physical interaction with many people is nearly impossible, a research project is quite versatile and I also thought it would allow me to concentrate deeper into my studies with truly what I want to study. I chose my project area to be CRISPR technology because along with the recent Nobel Prize awarded for the discovery of a new CRISPR technology and an arising curiosity for CRISPR after my experiment sparked more interest in CRISPR, so I decided to write a paper about CRISPR! I was intrigued by my previous summer experiment, (you can go check that out on this link!), of the CRISPR editing process, and decided to dig even deeper than before.

For today’s process, we started making the Agar plates. Using a funnel, I poured in the LB Agar media powder into the glass bottle (which was more successful than stupidly pouring the bottle into the bottle with the hope that I wouldn’t spill any powder like I did last time – which I FAILED).
Then, we poured in 150mL of distilled water (plastic jugs with a plastic hose). At first, we microwaved the Agar gel in the school cafeteria’s microwave, which did not have a lamp inside. So we had to microwave in 5 second intervals because we did not want it to overboil. But because of the risk, we microwaved it in the microwave in the teachers’ lounge, which fortunately, had a lamp. (but still, we were unable to see clearly)
The solution still seemed overly saturated, so while microwaving, we continuously gently swished the bottle around in circles. But since the liquid still wouldn’t melt, we microwaved it for 30 seconds, and the liquid accidentally overboiled. But thanks to my acquired knowledge from last time to swish the bottle between intervals, the liquid fully dissolved into a translucent solution.
I actually realized these Petri dishes had a demarcation line! Last time, I didn’t see them, so I just poured randomly and repoured into some dishes when the liquid was comparably lower than the other plates. But this time, thanks to the black table, I was able to notice the demarcation mark.
My bio teacher actually recommended me to use a plastic pipette (the transparent, soft ones that look like jellyfish) to slowly pipette onto the plates. This significantly reduced any errors of spilling on the table and air bubbles! I learned today that after pipetting the liquid onto the Petri dish, I should leave an inch or so of liquid still in the pipette to prevent air bubbles. And if air bubbles do form, I can press the pipette (sucked) and release when I direct the pipette tip onto the air bubble so the air bubble is sucked up. This helps the Agar to be more clearer.
It was really exciting to see finally a success in my Agar plating because in the last experiment, I assumed that Agar plates should be a golden yellow, but actually, I realized that the agar plates when held above a light, is nearly colorless.
However, I did struggle with evenly spreading out the agar solution because the agar solution hardened quite quickly (much faster than my previous experiment), so some regions of the plate were thicker than others.
For tomorrow’s experiment, I am going to cultivate some bacteria!
– Joanna Kim, April 27, 2021, 11:27 PM KST